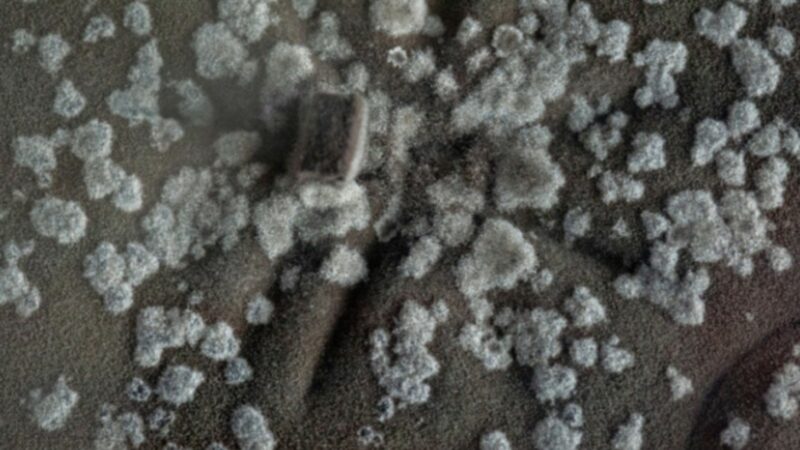

Këto kërpudha u rritën në një nga vendet më radioaktive në botë, dhe siç tregoi hulumtimi i Neli Zhdanova, ashtu si bimët kërkojnë rrezet e diellit, ky lloj kërpudhe tërhiqet nga rrezatimi jonizues.
Kërpudhat e zeza të rritura në rrënojat e lëna nga shpërthimi i centralit bërthamor të Çernobilit rriten më shpejt falë rrezatimit dhe në fakt “ushqehen” me të, sipas një studimi të shkencëtares Neli Zhdanova, i cili u pasua nga disa hulumtime të mëvonshme, shkruan BBC.
Sipas raportimeve, përfundimet e hulumtimit të saj ofrojnë shpresë për mundësinë e pastrimit të hapësirave radioaktive dhe madje tregojnë mënyra se si astronautët mund të mbrohen nga rrezatimi i dëmshëm gjatë udhëtimit në hapësirë.
Zhdanova i quajti kërpudhat “radiotropike” dhe zbulimet e saj në vitin 1997 i shtynë shkencëtarët në agjencinë amerikane hapësinore NASA të mendonin se muret e bëra nga kërpudha të tilla mund të ishin një formë mbrojtjeje për astronautët.
Siç doli gjatë hulumtimit, pigmenti melaninë është arsyeja pse këto kërpudha janë të zeza dhe vepron si një mburojë kundër rrezatimit jonizues.
Në vitin 2007, shkencëtarja bërthamore në Kolegjin e Mjekësisë Albert Einstein në Nju Jork, Ekaterina Dadachova, ndoqi punën e Zhdanova, duke zbuluar se rritja e kërpudhave të zeza përshpejtohet në prani të rrezatimit.
Siç rezulton, për mostrat e këtij lloji të kërpudhave të gjetura në Çernobil, as rrezatimi kozmik galaktik nuk është problem.
Gjatë hulumtimit në dhjetor 2018, mostrat u dërguan në Stacionin Ndërkombëtar Hapësinor, kujtoi BBC.
“Ne treguam se ato përparojnë dhe rriten edhe më mirë në hapësirë”, tha Nils Averes, një biokimist nga Universiteti i Floridës dhe një nga autorët e atij hulumtimi.
Rezultatet e të gjitha hulumtimeve çuan në shqyrtimin e mundësisë së prodhimit të mobiljeve dhe mureve nga këto kërpudha që mund të jetonin në Hënë ose në Mars.
Kjo lloj “mikroarkitekture”, nëse gjetjet e Dadač dhe Avereš rezultojnë të sakta, mund të përdoret si një mburojë kundër rrezatimit, një barrierë midis njeriut dhe stuhisë së rrezatimit kozmik galaktik.